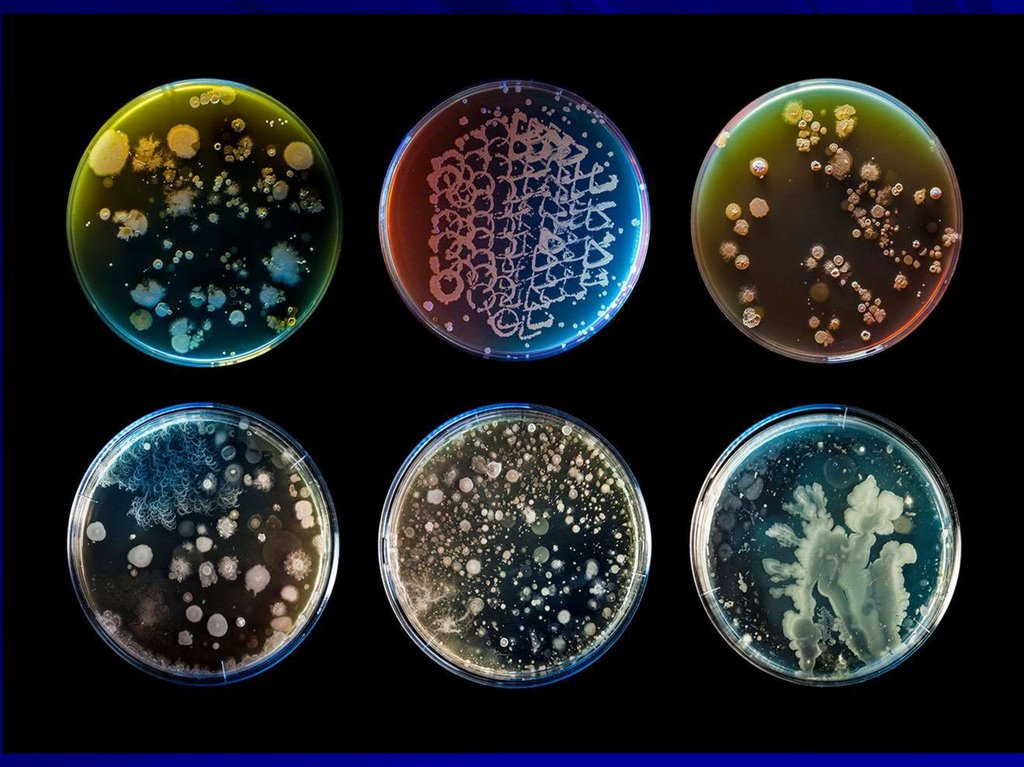

Similar presentations:
Основные определения микробиологии принципы таксономии и классификации микроорганизмов. Методы микроскопии
1. ОСНОВНЫЕ ОПРЕДЕЛЕНИЯ МИКРОБИОЛОГИИ ПРИНЦИПЫ ТАКСОНОМИИ И КЛАССИФИКАЦИИ МИКРООРГАНИЗМОВ МЕТОДЫ МИКРОСКОПИИ
2. Разделы современной микробиологии
Общая микробиологияЧастная микробиология
Промышленная микробиология и
биотехнология
Сельскохозяйственная
Ветеринарная
Космическая
Санитарная
Медицинская
3. ПРИНЦИПЫ КЛАССИФИКАЦИИ МИКРООРГАНИЗМОВ
Международный комитет посистематике прокариот
Международный журнал
систематической и эволюционной
микробиологии
определитель бактерий Берджи
Международный комитет по таксономии
вирусов
4.
5. ПРИНЦИПЫ КЛАССИФИКАЦИИ МИКРООРГАНИЗМОВ
Нумерический подход(фенотипический, феносистематика)
морфологические, тинкториальные,
культуральные, биохимические,
антигенные и др. свойства
6. ПРИНЦИПЫ КЛАССИФИКАЦИИ МИКРООРГАНИЗМОВ
Генетический(бактериальная геномная ДНК и 16S
рРНК)
1) секвенирование генов 16S рибосомальной
РНК (совп. 98-99% род)
2) геномное севенирование (совп.
последовательности 95-96% вид)
7. Полифазная таксономия
идентификацию видов бактерийпроводят на основе генетического
анализа в сочетании с наиболее
важными фенотипическими
характеристиками
MALDI-TOF - времяпролетная масс-спектрометрия
выделенной микробной культуры после ее матричноактивированной лазерной десорбции/ионизации
8. Полифазная таксономия
9.
10. Современная таксономия организмов
Домены(надцарства, империи)
Archaea
Bacteria
Eukarya
11.
Домен BacteriaProteobacteria
Firmicutes
Actinobacteria
Spirochaetes
Chlamydiae
Bacteroidetes
Типы
и др.
12.
Царство FungiGlomeromycota
Ascomycota
Basidiomycota
Типы
13.
класспорядок
семейство
род
вид
подвид
14. Семейство Staphylococcaceae Род Staphylococcus
Виды1. S. aureus
2. S. epidermidis
3. S. saprophyticus
Staphylococcus spp.
15. Монофилетический принцип
иерархическое разделениебиологических объектов с учетом их
происхождения от единого общего
предка внутри таксонов
(филогенетические деревья)
Филогенетические отношения
(расстояния) между различными
группами организмов определяются
методами молекулярной генетики
16.
Вид - эволюционно сложившаясяпопуляция микроорганизмов, имеющих
единое происхождение, генотип, среду
обитания и свойства, и способных
вызывать сходные процессы в
организме человека и/или внешней
среде
17.
Штамм - культураодного вида
микроорганизмов,
выделенная из
различных источников
(организма человека,
животного,
окружающей среды)
или из одного и того
же источника, но в
разное время
18.
Вариант (тип) - отличается отдельнымипризнаками от стандартного вида в
результате генетической изменчивости
Морфологические (морфовары),
биологические (биовары), различающиеся
по антигенной структуре (серовары или
антигеновары), экологическим нишам, в
которых они обитают (эковары), и
патогенности для определенных хозяев
(патовары)
19.
Изолят - вариант микроорганизма,непосредственно выделенный из
какого-либо источника, до получения
его полной характеристики
Клон – культура микроорганизмов,
полученная из одной особи
Чистая культура - микробные особи
одного и того же вида, выращенные на
питательной среде (потомки одной
микробной клетки=клон)
20.
21.
22. Виды микроскопических методов
СветоваяФазово-контрастная
Темнопольная
R ~ λ / 2A
Люминесцентная
Конфокальная
Атомно-силовая
Электронная
(просвечивающая, сканирующая)
23. Ключевые характеристики
Разрешающая способность – этонаименьшее расстояние между двумя
точками, при котором они еще
воспринимаются раздельно, а не
сливаются в одну
Контрастность – отношение яркости
светлых и темных участков
изображения
24.
РАЗРЕШЕНИЕcredit: http://www.microscopyu.com/tutorials/
Функция рассеяния точки
(Point spread function)
25. Световая микроскопия
+++Простота
использования
--Необходимость
фиксации и окраски
микробных препаратов
26. Иммерсионный объектив
Для увеличения числовой апертуры(зависит от коэф. преломления среды и
линзы) объектив погружают в специальную
иммерсионную жидкость, что обеспечивает
отсутствие воздушной прослойки между
препаратом и объективом
При использовании масляной иммерсии
принципиально достижимое разрешение
микроскопа составляет 1/3 длины волны
использованного света
27. Фазово-контрастная микроскопия
При прохождении световой волны черезнеокрашенные объекты меняется ее фаза
При применении специального фазового
устройства происходит преобразование
фазовых изменений световой волны в
амплитудные, различимые глазом
Черно-белое изображение с высокой
контрастностью
28.
Интерференционныймаксимум
Интерференционный
минимум
Интерференционный
минимум
29. Фазово-контрастная микроскопия
+++• Микроскопия
нативных объектов
• Высокая
контрастность и
разрешение
--• Подходит только
для тонких
препаратов
30.
31. Темнопольная микроскопия
32. Темнопольная микроскопия
+++• Микроскопия
нативных препаратов
--• Низкая контрастность
• Повреждение
препарата ярким
светом
33. Люминесцентная (флуоресцентная) микроскопия
Флуорохромы красители, которыеспособны поглощать свет
определенной длины
волны, а затем излучать с
увеличением длины волны
34.
Флуорохромы имеютразные спектры
возбуждения и
флуореценции, что
позволяет использовать
для окраски в одном
препарате несколько
красителей
одновременно
35.
+++• Изучение нативных препаратов
• Высокая чувствительность и
специфичность
• Одновременное использование
нескольких флюорохромов и изучение
различных молекул
• Визуализация in vitro и in vivo
--- Фотообесцвечивание – постепенное фотохимическое
разрушение флюорофора
- Фототоксичность некоторых флюорофоров
36. Конфокальная микроскопия
ЛКФМ основана на компьютернойлюминесцентной микроскопии
Препарат обычно красят флюорохромом
(например, акридиновый оранжевый,
флуоресцеин и т.д.)
Источники света – лазеры (фокусирование луча
в точку минимального диаметра на препарате)
Конфокальная диафрагма отсекает постороннее
излучение из соседних точек в препарате
Можно наблюдать объект в режиме реального
времени (оценка функции клетки – подвижность
и т.д.)
Сканируя лазерным лучом препарат, можно
получить его трехмерное изображение, оценить
экспрессию окрашенных белков в клетке и т.д.)
37.
+++• Удаление фонового
шума за счет малой
расходимости
лазерного пучка
• Контроль глубины
сканирования
• 3D визуализация
38.
Функция рассеяния точкиОбычный
X
Z
Конфокальный
X
Z
39.
40. Принципы атомно-силовой микроскопии
АСМ основана на оценке сил взаимодействия междуультратонким датчиком микроскопа (кантилевером) и
поверхностью изучаемого препарата
Препарат обычно помещают на пористую подложку
В АСM препарат не облучается. Лазеры используются для
точной оценки положения датчика (кантилевера)
По изменению сил взаимодействия можно контролировать
объект в режиме реального времени (оценка функции
клетки – транспорт молекул, спорообразование и т.д.)
Разрешение АСМ очень высоко – молекулярный уровень нанометры
Сканируя кантилевером препарат, можно получить его
трехмерное изображение, оценить вязкость мембраны,
положение белков в клетке и т.д.
41.
42.
43. Просвечивающая электронная микроскопия
пучок электронов ориентирован исфокусирован электромагнитными
линзами на специально подготовленный
тонкий образец (до 100 нм толщиной).
При прохождении через образец часть
электронов рассеивается в зависимости
от локальных особенностей структуры и
плотности исследуемого препарата.
Эти электроны собираются и
фокусируются электромагнитной линзой
объектива, что создает изображение
образца на люминесцентном экране,
излучающем свет под действием
электронов.
разрешение в пределах
0,1-1 нм
44. Сканирующая электронная микроскопия
! Требуется вакуум, тонкий идегидратированный объект
+++
3D
Сильное увеличение
--Черно-белое изображение
Сложное оборудование и
подготовка проб
Ниже разрешающая
способность
Фиксированные препараты

biology
biology








